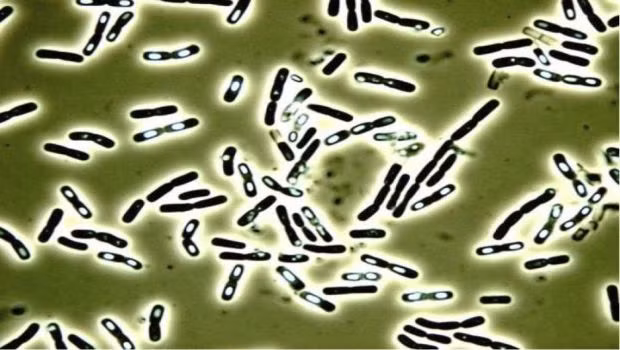
Những bào tử vi khuẩn này vẫn có khả năng sống sót sau khi gạo đã nấu chín thành cơm. Vì vậy, sau khi cơm chín, nếu để cơm ở nhiệt độ phòng trong thời gian dài thì những bào tử này có thể phát triển thành vi khuẩn có thể sản sinh ra những độc tố gây bệnh, cuối cùng dẫn đến ngộ độc thực phẩm.

![[GALLERY] Nhân viên Google tạo tool AI gây sốt rồi bị sa thải](https://cdn.kienthuc.net.vn/images/190e30c7c04ee6e7103089027c41b3a9d71d9192b485cfe54de206e9cfade6f5baf95a50518cc744c6184e1388024d95/go-1.png.avif)

![[GALLERY] Chi tiết Hyundai Elantra 2027 "bằng xương bằng thịt" vừa ra mắt](https://cdn.kienthuc.net.vn/images/9296f0377c64048406d89ea0c83995cbaa2f09cb5010a93da44658e5ded0d5cc3f70a1dbcdef0847d6497f58d19507be/1.jpg.avif)
![[GALLERY] 5 ứng dụng Android top đầu nhưng chuyên gia khuyên đừng cài](https://cdn.kienthuc.net.vn/images/190e30c7c04ee6e7103089027c41b3a9e5dea2dc7260e26e3f4e16a54ffd6245508736cee69535b01ae8723580341b28/tu-8.png.avif)
![[GALLERY] Xe ga Suzuki SUI 2026 "uống xăng" 47 km/lít, giá 63,9 triệu đồng](https://cdn.kienthuc.net.vn/images/9296f0377c64048406d89ea0c83995cbaa2f09cb5010a93da44658e5ded0d5ccfd1a109ec9763c03866ed1de59f71dba/7-2119.jpg.avif)
![[GALLERY] Thiết bị tí hon giúp SK Hynix lật đổ Samsung sau 14 năm](https://cdn.kienthuc.net.vn/images/190e30c7c04ee6e7103089027c41b3a959bcdcfdc17685ed809faa3366087bc683a26788e95d097b0f332403453a42ce/ban-4.png.avif)
![[GALLERY] "Đập thùng" Kawasaki ZX-10R mới tại Việt Nam, rẻ hơn bản cũ tới tới 216 triệu](https://cdn.kienthuc.net.vn/images/9296f0377c64048406d89ea0c83995cbaa2f09cb5010a93da44658e5ded0d5ccaca769c992c57ff8b0e3af40553a75bd/1-6652.jpg.avif)
![[GALLERY] Suzuki eVitara hơn 1,2 tỷ đồng tại Malaysia, sẽ khó về Việt Nam](https://cdn.kienthuc.net.vn/images/9296f0377c64048406d89ea0c83995cbaa2f09cb5010a93da44658e5ded0d5cc15486499e117ee495e214b3f8dee1c18/11-5475.jpg.avif)

Toyota tiếp tục điều chỉnh kế hoạch sản xuất do biến động địa chính trị tại Trung Đông và áp lực chuỗi cung ứng. Đáng chú ý, mẫu RAV4 chịu tác động nhiều nhất.
![[GALLERY] Chi tiết Hyundai Elantra 2027 "bằng xương bằng thịt" vừa ra mắt](https://cdn.kienthuc.net.vn/images/fa6fa22794e1049e63e79fd6d1d3f051aa2f09cb5010a93da44658e5ded0d5cc3f70a1dbcdef0847d6497f58d19507be/1.jpg.avif)
![[GALLERY] Xe ga Suzuki SUI 2026 "uống xăng" 47 km/lít, giá 63,9 triệu đồng](https://cdn.kienthuc.net.vn/images/fa6fa22794e1049e63e79fd6d1d3f051aa2f09cb5010a93da44658e5ded0d5ccfd1a109ec9763c03866ed1de59f71dba/7-2119.jpg.avif)
![[GALLERY] "Đập thùng" Kawasaki ZX-10R mới tại Việt Nam, rẻ hơn bản cũ tới tới 216 triệu](https://cdn.kienthuc.net.vn/images/fa6fa22794e1049e63e79fd6d1d3f051aa2f09cb5010a93da44658e5ded0d5ccaca769c992c57ff8b0e3af40553a75bd/1-6652.jpg.avif)
![[GALLERY] Suzuki eVitara hơn 1,2 tỷ đồng tại Malaysia, sẽ khó về Việt Nam](https://cdn.kienthuc.net.vn/images/fa6fa22794e1049e63e79fd6d1d3f051aa2f09cb5010a93da44658e5ded0d5cc15486499e117ee495e214b3f8dee1c18/11-5475.jpg.avif)
![[GALLERY] Nhân viên Google tạo tool AI gây sốt rồi bị sa thải](https://cdn.kienthuc.net.vn/images/fc6b1457645b26575fcbba0a62d9d7d4d71d9192b485cfe54de206e9cfade6f5baf95a50518cc744c6184e1388024d95/go-1.png.avif)
Công cụ AI giúp Gmail, Drive và Sheets hoạt động tự động đã gây tiếng vang lớn, nhưng tác giả của nó lại bị Google sa thải đầy bất ngờ.

Xem tử vi hàng ngày, tử vi 12 con giáp hôm nay cho thấy tuổi Thân có sự nghiệp thành công, có thể được thăng chức và tài lộc vượng phát.
![[GALLERY] Chi tiết Hyundai Elantra 2027 "bằng xương bằng thịt" vừa ra mắt](https://cdn.kienthuc.net.vn/images/fa6fa22794e1049e63e79fd6d1d3f051aa2f09cb5010a93da44658e5ded0d5cc3f70a1dbcdef0847d6497f58d19507be/1.jpg.avif)
Hãng Hyundai đã chính thức ra mắt thế hệ thứ 8 hoàn toàn mới của mẫu sedan Avante 2027 tại Hàn Quốc. Tại một số thị trường khác, xe có tên là Hyundai Elantra.
![[GALLERY] 5 ứng dụng Android top đầu nhưng chuyên gia khuyên đừng cài](https://cdn.kienthuc.net.vn/images/fc6b1457645b26575fcbba0a62d9d7d4e5dea2dc7260e26e3f4e16a54ffd6245508736cee69535b01ae8723580341b28/tu-8.png.avif)
Chuyên gia Android cảnh báo 5 ứng dụng phổ biến tiềm ẩn rủi ro về bảo mật, quyền riêng tư và nhiều tính năng đã trở nên không còn cần thiết.
![[GALLERY] Xe ga Suzuki SUI 2026 "uống xăng" 47 km/lít, giá 63,9 triệu đồng](https://cdn.kienthuc.net.vn/images/fa6fa22794e1049e63e79fd6d1d3f051aa2f09cb5010a93da44658e5ded0d5ccfd1a109ec9763c03866ed1de59f71dba/7-2119.jpg.avif)
Suzuki SUI 2026 vừa ra mắt tại Đài Loan, mẫu xe ga này có mức tiêu thụ nhiên liệu khoảng 47,18km/lít kèm giá bán 77.000 Tân Đài tệ (khoảng 63,9 triệu đồng)
![[GALLERY] Thiết bị tí hon giúp SK Hynix lật đổ Samsung sau 14 năm](https://cdn.kienthuc.net.vn/images/fc6b1457645b26575fcbba0a62d9d7d459bcdcfdc17685ed809faa3366087bc683a26788e95d097b0f332403453a42ce/ban-4.png.avif)
Từ một canh bạc bị hoài nghi đến cú bứt phá lịch sử, chip HBM đã giúp SK Hynix vượt mặt Samsung, trở thành công ty giá trị nhất Hàn Quốc.
![[GALLERY] "Đập thùng" Kawasaki ZX-10R mới tại Việt Nam, rẻ hơn bản cũ tới tới 216 triệu](https://cdn.kienthuc.net.vn/images/fa6fa22794e1049e63e79fd6d1d3f051aa2f09cb5010a93da44658e5ded0d5ccaca769c992c57ff8b0e3af40553a75bd/1-6652.jpg.avif)
Sau 8 tháng kể từ khi được ra mắt, mẫu superbike Kawasaki Ninja ZX-10R 2026 đã có mặt tại Việt Nam. Thế hệ mới ra mắt giảm hàng trăm triệu so với đời cũ.
![[GALLERY] Suzuki eVitara hơn 1,2 tỷ đồng tại Malaysia, sẽ khó về Việt Nam](https://cdn.kienthuc.net.vn/images/fa6fa22794e1049e63e79fd6d1d3f051aa2f09cb5010a93da44658e5ded0d5cc15486499e117ee495e214b3f8dee1c18/11-5475.jpg.avif)
Sau Thái Lan và Indonesia, đến lượt Malaysia đón nhận mẫu SUV điện cỡ nhỏ Suzuki eVitara. Xe có giá bán 188.000 RM (khoảng 1,22 tỷ đồng), chưa bao gồm bảo hiểm.
![[GALLERY] Điều hòa di động Fujihome 2026, mẫu nào đáng mua nhất?](https://cdn.kienthuc.net.vn/images/fc6b1457645b26575fcbba0a62d9d7d42581dc2ada4234006599d1bb61c38e22baf95a50518cc744c6184e1388024d95/fu-1.png.avif)
Fujihome 2026 ra mắt 4 mẫu điều hòa di động mới với nhiều nâng cấp về làm lạnh, tiết kiệm điện và độ ồn, phù hợp đa dạng nhu cầu sử dụng.
![[GALLERY] OpenAI, Anthropic đổi hướng, cuộc chiến AI tỷ USD mới](https://cdn.kienthuc.net.vn/images/fc6b1457645b26575fcbba0a62d9d7d4bec406421e7fca95a08a888f3a3853c8baf95a50518cc744c6184e1388024d95/gn-1.png.avif)
Không còn chatbot hay lập trình, OpenAI, Anthropic và DeepMind đang đổ hàng tỷ USD vào y sinh, mở ra cuộc đua AI lớn nhất thập kỷ.
![[GALLERY] Tận thấy Mazda 6e từ 935 triệu cập bến Thái Lan, có về Việt Nam?](https://cdn.kienthuc.net.vn/images/fa6fa22794e1049e63e79fd6d1d3f051aa2f09cb5010a93da44658e5ded0d5cc85f0e841068f73245bc65667e5b8418f/8-6243.jpg.avif)
Loạt xe Mazda 6e đã cập cảng Thái Lan để chuẩn bị bàn giao, làm dấy lên câu hỏi liệu mẫu sedan điện này có về Việt Nam nhằm thay thế Mazda6 đã ngừng bán?
![[GALLERY] MPV BYD M9 bản dịch vụ giá rẻ cập bến đại lý, chờ ngày mở bán](https://cdn.kienthuc.net.vn/images/fa6fa22794e1049e63e79fd6d1d3f051aa2f09cb5010a93da44658e5ded0d5cc86b8bd89cc6ed5c35a4cabb399039ee9/7-3851.jpg.avif)
Mặc dù BYD M9 (Linghui M9) bản chạy dịch vụ đã xuất hiện tại các showroom trên toàn Trung Quốc nhưng hãng xe này vẫn chưa công bố giá bán chính thức.
![[GALLERY] Tin nhắn lạ xuất hiện, coi chừng điện thoại bị theo dõi](https://cdn.kienthuc.net.vn/images/fc6b1457645b26575fcbba0a62d9d7d42162370b0e9e4ba62bcb65a573afd5ff8122ab99d5a68f47d521ca0d013fd909/tin-1.png.avif)
Những tin nhắn bất thường trên điện thoại có thể là dấu hiệu thiết bị bị cài phần mềm gián điệp, đe dọa nghiêm trọng đến dữ liệu cá nhân.
![[GALLERY] Honda City 2026 từ 450 triệu đồng - thiết kế đẹp, công nghệ xịn hơn](https://cdn.kienthuc.net.vn/images/fa6fa22794e1049e63e79fd6d1d3f051aa2f09cb5010a93da44658e5ded0d5cc7c2a70a373149bfd980eafdc0440c7a2/8.jpg.avif)
Honda City facelift 2026 vừa ra mắt tại Thái Lan với bản sedan 4 cửa và hatchback 5 cửa. Xe được điều chỉnh mạnh về thiết kế, bổ sung nhiều trang bị mới...

Xem tử vi hàng ngày, tử vi 12 con giáp hôm nay cho thấy tuổi Tý mở ra cơ hội bứt phá, sự nghiệp "lên hương" và tiền bạc dồi dào.
![[GALLERY] RF Online Next gây sốc, huyền thoại 20 năm hồi sinh ngoạn mục](https://cdn.kienthuc.net.vn/images/fc6b1457645b26575fcbba0a62d9d7d4fe59cba704dba9818dc512afa7f442bcffe4cc997d19e3f0e6b9d93b56842403/rf-5.png.avif)
Sau hơn 20 năm ngủ quên, RF Online chính thức trở lại với RF Online Next, sở hữu đồ họa Unreal Engine 5 và chiến trường quy mô lớn gây sốt.
![[GALLERY] Điện thoại không rơi vẫn nứt kính, thủ phạm gây sốc ít ai ngờ](https://cdn.kienthuc.net.vn/images/fc6b1457645b26575fcbba0a62d9d7d4a69b10b6e27efb7624afeedd980a7bf12ecd2cc4ccacbeb970a1fc67c6faba48/nut-4.png.avif)
Nhiều người thắc mắc vì sao điện thoại không hề rơi nhưng kính cường lực vẫn nứt vỡ. Nguyên nhân lại đến từ một thói quen rất phổ biến hàng ngày.
![[GALLERY] BYD Atto 2 chạy 45km "không uống 1 giọt xăng", rộng cửa về Việt Nam](https://cdn.kienthuc.net.vn/images/fa6fa22794e1049e63e79fd6d1d3f051aa2f09cb5010a93da44658e5ded0d5cc47561cd0d0282bd855364161751495c1/8-3711.jpg.avif)
Mẫu xe SUV cỡ nhỏ BYD Atto 2 2026 phiên bản hybrid sạc điện DM-i đã bất ngờ được đưa đến Philippines để trưng bày như dấu hiệu cho việc xe sắp được bán ra.
![[GALLERY] Hyundai Elantra 2027 ra mắt - thiết kế lớn hơn, công nghệ vượt trội](https://cdn.kienthuc.net.vn/images/fa6fa22794e1049e63e79fd6d1d3f051aa2f09cb5010a93da44658e5ded0d5cc1567fca24fc91e05eab85aa0ed4de221/1-9144.jpg.avif)
Hyundai vừa ra mắt thế hệ mới của mẫu sedan Hyundai Avante 2027 tại Hàn Quốc. Tại một số thị trường trong đó có Việt Nam, xe có tên là Hyundai Elantra.
![[GALLERY] Hongqi E-HS9 2026 ra mắt Thái Lan - SUV hạng sang điện giá 2,5 tỷ](https://cdn.kienthuc.net.vn/images/fa6fa22794e1049e63e79fd6d1d3f051aa2f09cb5010a93da44658e5ded0d5cc7f1035b1d98b81c88af09f5d017fd039/3-575.jpg.avif)
Mẫu SUV điện hạng sang Hongqi E-HS9 vừa chính thức ra mắt tại thị trường Thái Lan, sau Singapore. Đây là phiên bản tay lái nghịch dành cho Đông Nam Á.